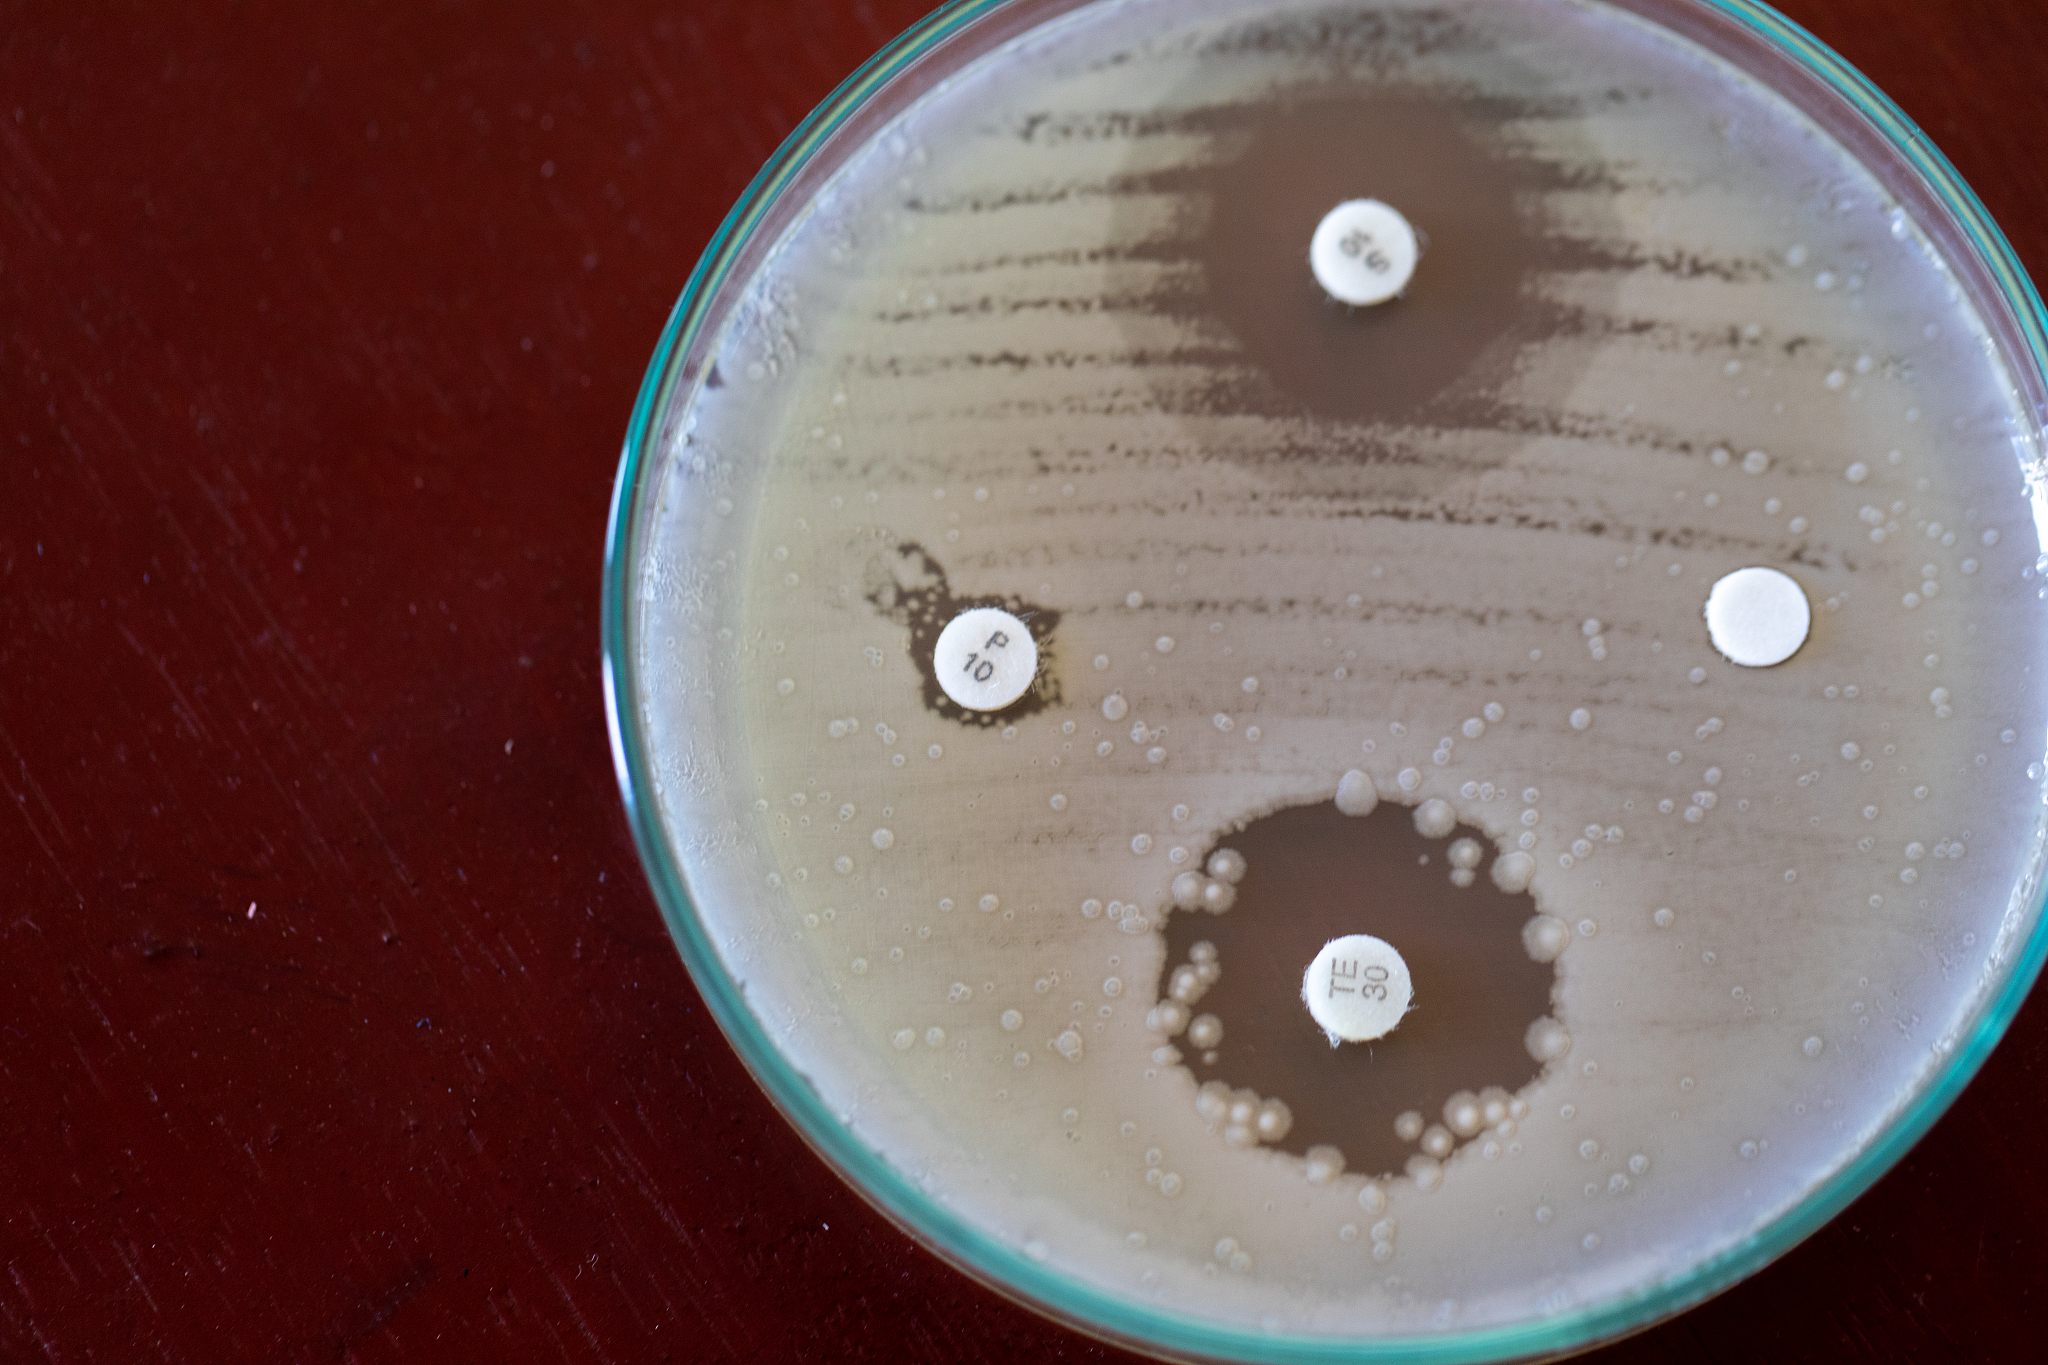
如何培养酵母菌

如何培养酵母菌
酵母菌是一种单细胞真菌,可以用于发酵面包、啤酒、葡萄酒等食品和饮料。下面是培养酵母菌的步骤:
-
准备培养基:将酵母菌需要的营养物质溶解在水中,如麦芽提取物、葡萄糖、酵母营养素等,然后加热灭菌。
-
培养酵母菌:将培养基倒入培养皿中,用火焰消毒的铁环取少量酵母菌,点在培养基表面,然后盖上培养皿盖子。
-
培养条件:将培养皿放在恒温箱中,温度一般为28-30℃,并保持培养皿内部湿润。酵母菌需要光照,因此可以放在灯箱下进行培养。
-
观察生长:培养2-3天后,可以观察到酵母菌在培养基上的生长情况。如果需要大量培养酵母菌,可以将培养皿中的酵母菌转移至更大的培养容器中,继续培养。
注意事项:
-
培养容器和工具需要消毒,避免杂菌污染。
-
培养皿和培养基需要严格按照配方制备,以保证酵母菌能够正常生长。
-
培养条件需要严格控制,如温度、湿度、光照等,以避免影响酵母菌生长。
原文地址: https://www.cveoy.top/t/topic/eD24 著作权归作者所有。请勿转载和采集!